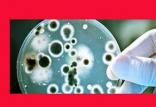
تب مالت,اخبار پزشکی,خبرهای پزشکی,بهداشت

حوزه بهداشت و رفاه
-

رئیس سازمان نظام پزشکی: بیش از ۳۰ هزار پزشک عمومی طبابت نمیکنند
رئیس سازمان نظام پزشکی با اشاره به آمار پزشکان عمومی غیرفعال در حوزه طبابت گفت: بر اساس بررسیهای انجامشده، بیش از ۳۰ هزار پزشک عمومی در حال حاضر در
[ادامه] -

فروش ویژه تجهیزات دندانپزشکی
ما در فروشگاه دنت لند با تجربه تخصصی در تأمین و تجهیز مطبها و کلینیکهای دندانپزشکی، بهخوبی میدانیم که مهمترین دغدغه دندانپزشکان، تأمین تجهیزات ب
[ادامه] -

تولد نوزاد با رحم پیوندی از اهدا کننده متوفی
تولد یک نوزاد پسر از نخستین پیوند رحم انجام شده در انگلیس به زوج های خواستار فرزند امید تازه ای بخشیده است. این رحم از یک فرد فوت شده اهدا شده بود.
[ادامه] -

ویزیت یکمیلیونی برای پزشکان عمومی تصویب نمیشود
دبیر شورایعالی بیمه سلامت گفت: هنوز جمعبندی نهایی درباره میزان افزایش تعرفههای پزشکی صورت نگرفته است.
[ادامه] -

مردان ایرانی بیشتر مریض می شوند، کمتر دکتر میروند
شرایط شغلی، فعالیتهای پرخطر و قرار گرفتن بیشتر در معرض حوادث و تروما از جمله عواملی است که آسیبپذیری مردان را افزایش میدهد.
[ادامه]

هپاتیت، دومین قاتل عفونی جهان
هپاتیت پس از سل، دومین قاتل عفونی در جهان است، با اینکه این بیماری قابل پیشگیری و درمان است اما حدود ۸۰ درصد مبتلایان به هپاتیت، فاقد اقدامات مرتبط ب
[ادامه] رئیس کنگره اپتومتری ایران مطرح کرد؛
رئیس کنگره اپتومتری ایران مطرح کرد؛ ۹۰ هزار نابینا در ایران/۸۰ درصد اختلالات بینایی قابل پیشگیری است
رئیس بیست و دومین کنگره انجمن علمی اپتومتری ایران، با اشاره به وجود ۹۰ هزار نابینا در کشور، گفت: ۸۰ درصد اختلالات منجر به نابینایی و کم بینایی قابل پ
[ادامه]
نیمی از ایرانیها به هفتاد سالگی نمیرسند!
معاون وزارت بهداشت میگوید نزدیک نیمی از مرگها در ایران زودرس هستند و زیر ۷۰ سالگی رخ میدهند.
[ادامه]
بازداشت شدگان سازمان غذا و دارو در انتظار تصمیم مراجع قضایی
مدیرکل دفتر نظارت و ارزیابی وزارت بهداشت گفت: جرم بازداشت شدگان سازمان غذا و دارو ثابت نشده است و مراجع قضایی باید در این زمینه تصمیمگیری کنند.
[ادامه]
چالشهای زوجهای نابارور که تعدادشان از ۳ میلیون هم گذشته
اگرچه در ظاهر ناباروری یک نارسایی فیزیولوژیک شمرده میشود اما جنبههای روانی و اجتماعی گستردهای پیدا میکند.
[ادامه]
روش جدید درمان سرطان در کشور عملیاتی میشود
رئیس انجمن رادیوتراپی انکولوژی ایران گفت: روش جدید درمان سرطان در ایران به اجرا در میآید اما به زمان نیاز است تا میزان تأثیر آن بر روی سرطان ها مشخص
[ادامه]
معاون وزیر بهداشت: بیش از ۹۹ درصد تبلیغات حوزه پزشکی و دارویی غیر قانونی و فاقد مجوزند
معاون کل وزارت بهداشت گفت: تمام داروهایی که از طریق شبکههای ماهوارهای تبلیغ میشوند، تقلبی است و از شبکههای غیررسمی و قاچاق وارد شدهاند.
[ادامه]
هشدار وزیر بهداشت به بیمارستانها: بیماران تنگدست را باید پذیرش کنید
وزیر بهداشت، در ارتباط با عدم پذیرش بیماران تنگدست در بیمارستانهای دولتی، هشدار داد.
[ادامه] کارشناس معاینات بالینی پزشکی قانونی:
کارشناس معاینات بالینی پزشکی قانونی: مجوز سقط درمانی به بیش از ۱۹هفتگی داده نمیشود
کارشناس معاینات بالینی سازمان پزشکی قانونی گفت: چنانچه بیش از ۱۹ هفته از سن حاملگی (LMP) بگذرد حتی با وجود اختلالات جنینی موجب حرج مادر باشد، امکان ص
[ادامه]
ماجرای یک میلیارد یورو ارز گم شده تجهیزات پزشکی
'یک میلیارد و ۳۰۰ میلیون یورو ارز رسمی کشور در حوزه تجهیزات پزشکی گم شد'، '۱۰ شرکت واردکننده تجهیزات پزشکی ارزبگیر به تعهداتشان عمل نکردهاند'، 'ابه
[ادامه]
هشدار جدی WHO در مورد مضرات سیگار الکترونیک
سازمان جهانی بهداشت (WHO) اعلام کرد: بیتردید سیگارهای الکترونیکی برای سلامت مضر هستند.
[ادامه]
وزیر بهداشت: جامعه شادی نداریم
وزیر بهداشت با تاکید بر لزوم ایجاد فضای شادی و نشاط در کشور، گفت: برخی با کج سلیقگی سعی در ایجاد فضای غم و اندوه و سرخوردگی در جامعه دارند و سعی میک
[ادامه]
مسمومیت ۴۹ نفر در تالار عروسی در ارومیه
رئیس مرکز حوادث و فوریتهای پزشکی آذربایجان غربی از مسمومیت ۴۹ نفر در تالار عروسی در ارومیه خبر داد.
[ادامه]
چرا داروهای برند ژنریک تفاوت قیمت دارند؟
رئیس سازمان غذا و دارو، در مورد تفاوت قیمت داروهای برند ژنریک در کشور، توضیحاتی ارائه داد.
[ادامه]
اجرای کامل پرونده الکترونیک سلامت تا نیمه سال آینده/ جزئیات معافیت مالیاتی پزشکان
عضو کمیسیون بهداشت و درمان مجلس درخصوص مباحث مطرح شده در جلسه اعضای کمیسیون بهداشت و درمان مجلس و روسای دانشگاههای علوم پزشکی با وزیر بهداشت توضیحات
[ادامه]
ابتلای بیش از ۱۶هزار تن در کشور به تب مالت در سال گذشته
رییس اداره مدیریت بیماریهای قابل انتقال بین انسان و حیوان وزارت بهداشت، مصرف شیر غیر پاستوریزه، فرآوردههای لبنی تولید شده بدون نظارت، تماس مستقیم ب
[ادامه]
طرح پزشک خانواده تا پایان امسال در ۵۰ درصد از استانهای کشور اجرایی میشود
وزیر بهداشت، درمان و آموزش پزشکی با اشاره به اشغال کمتر از ۳۰ درصدی ۵ هزار تخت بیمارستانی در کشور، گفت: تا پایان سال جاری طرح پزشک خانواده در ۵۰ درصد
[ادامه] رئیس پژوهشکده علوم بهداشتی جهاد دانشگاهی:
رئیس پژوهشکده علوم بهداشتی جهاد دانشگاهی: ۹۸ درصد مردم خود درمانی میکنند
رئیس پژوهشکده علوم بهداشتی جهاد دانشگاهی گفت: ۹۴/۶ درصد مردم اطلاعی از سواد سلامت ندارند و با وجود عدم شناخت مردم از وضعیت خودمراقبتی، ۹۸ درصد مردم خ
[ادامه] عضو انجمن بینالمللی ضد دخانیات:
عضو انجمن بینالمللی ضد دخانیات: ۲۲ درصد دانشجویان سال آخر پزشکی به دخانیات اعتیاد دارند
یک فوق متخصص ریه گفت: ۴ تا ۶ درصد دانشجویان رشتههای پزشکی در بدو ورود به دانشگاه به دخانیات اعتیاد دارند اما در سال آخر تحصیل این آمار به ۲۲ درصد می
[ادامه]
وزیر بهداشت: ۲ تابعیتی بودن من کذب محض است
وزیر بهداشت گفت: شایعه دوتابعیتی بودن من کذب محض است و جز تخریب دولت هدف دیگری ندارد.
[ادامه] بیوگرافی هیثم بن طارق آل سعید؛ حاکم عمان
بیوگرافی هیثم بن طارق آل سعید؛ حاکم عمانتاریخ تولد: ۱۱ اکتبر ۱۹۵۵
محل تولد: مسقط، مسقط و عمان
محل زندگی: مسقط
حرفه: سلطان و نخست وزیر کشور عمان
سلطنت: ۱۱ ژانویه ۲۰۲۰
پیشین: قابوس بن سعید
 زندگینامه بزرگمهر بختگان حکیم بزرگ ساسانی
زندگینامه بزرگمهر بختگان حکیم بزرگ ساسانیتاریخ تولد: ۱۸ دی ماه د ۵۱۱ سال پیش از میلاد
محل تولد: خروسان
لقب: بزرگمهر
حرفه: حکیم و وزیر
دوران زندگی: دوران ساسانیان، پادشاهی خسرو انوشیروان
 بیوگرافی صبا آذرپیک روزنامه نگار سیاسی و ماجرای دستگیری وی
بیوگرافی صبا آذرپیک روزنامه نگار سیاسی و ماجرای دستگیری ویتاریخ تولد: ۱۳۶۰
ملیت: ایرانی
نام مستعار: صبا آذرپیک
حرفه: روزنامه نگار و خبرنگار گروه سیاسی روزنامه اعتماد
آغاز فعالیت: سال ۱۳۸۰ تاکنون
 بیوگرافی روزنامه نگار سیاسی؛ یاشار سلطانی و حواشی وی
بیوگرافی روزنامه نگار سیاسی؛ یاشار سلطانی و حواشی ویملیت: ایرانی
حرفه: روزنامه نگار فرهنگی - سیاسی، مدیر مسئول وبگاه معماری نیوز
وبگاه: yasharsoltani.com
شغل های دولتی: کاندید انتخابات شورای شهر تهران سال ۱۳۹۶
حزب سیاسی: اصلاح طلب
 زندگینامه امامزاده صالح تهران و محل دفن ایشان
زندگینامه امامزاده صالح تهران و محل دفن ایشاننام پدر: اما موسی کاظم (ع)
محل دفن: تهران، شهرستان شمیرانات، شهر تجریش
تاریخ تاسیس بارگاه: قرن پنجم هجری قمری
روز بزرگداشت: ۵ ذیقعده
خویشاوندان : فرزند موسی کاظم و برادر علی بن موسی الرضا و برادر فاطمه معصومه
 زندگینامه شاه نعمت الله ولی؛ عارف نامدار و شاعر پرآوازه
زندگینامه شاه نعمت الله ولی؛ عارف نامدار و شاعر پرآوازهتاریخ تولد: ۷۳۰ تا ۷۳۱ هجری قمری
محل تولد: کوهبنان یا حلب سوریه
حرفه: شاعر و عارف ایرانی
دیگر نام ها: شاه نعمتالله، شاه نعمتالله ولی، رئیسالسلسله
آثار: رسالههای شاه نعمتالله ولی، شرح لمعات
درگذشت: ۸۳۲ تا ۸۳۴ هجری قمری
 بیوگرافی نیلوفر اردلان؛ سرمربی فوتسال و فوتبال بانوان ایران
بیوگرافی نیلوفر اردلان؛ سرمربی فوتسال و فوتبال بانوان ایرانتاریخ تولد: ۸ خرداد ۱۳۶۴
محل تولد: تهران
حرفه: بازیکن سابق فوتبال و فوتسال، سرمربی تیم ملی فوتبال و فوتسال بانوان
سال های فعالیت: ۱۳۸۵ تاکنون
قد: ۱ متر و ۷۲ سانتی متر
تحصیلات: فوق لیسانس مدیریت ورزشی
 بیوگرافی حمیدرضا آذرنگ؛ بازیگر سینما و تلویزیون ایران
بیوگرافی حمیدرضا آذرنگ؛ بازیگر سینما و تلویزیون ایرانتاریخ تولد: تهران
محل تولد: ۲ خرداد ۱۳۵۱
حرفه: بازیگر، نویسنده، کارگردان و صداپیشه
تحصیلات: روانشناسی بالینی از دانشگاه آزاد رودهن
همسر: ساناز بیان
 بیوگرافی محمدعلی جمال زاده؛ پدر داستان های کوتاه فارسی
بیوگرافی محمدعلی جمال زاده؛ پدر داستان های کوتاه فارسیتاریخ تولد: ۲۳ دی ۱۲۷۰
محل تولد: اصفهان، ایران
حرفه: نویسنده و مترجم
سال های فعالیت: ۱۳۰۰ تا ۱۳۴۴
درگذشت: ۲۴ دی ۱۳۷۶
آرامگاه: قبرستان پتی ساکونه ژنو

















